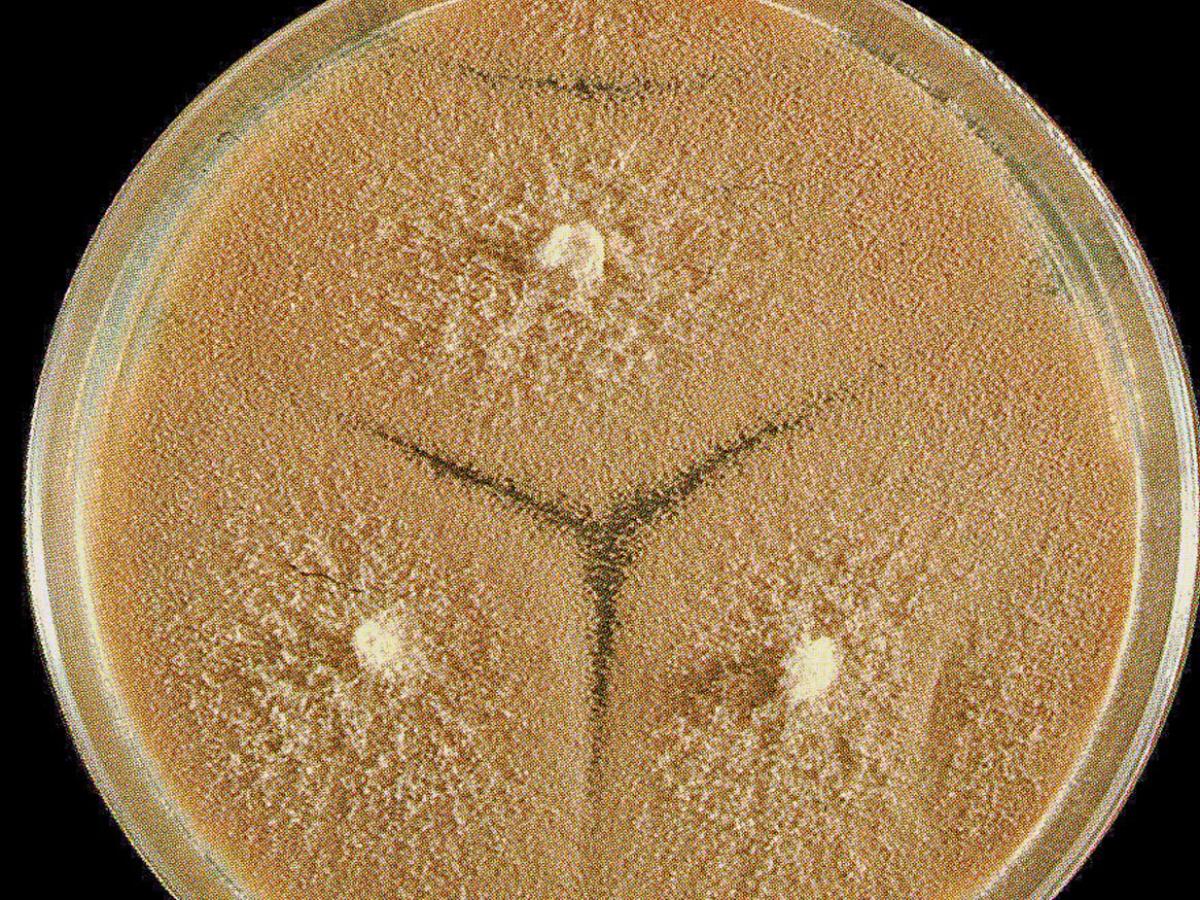
Culture

Status message
Correct! Excellent, you have really done well. Please find additional information below.
Unknown 56 = Scopulariopsis brevicaulis
Direct microscopy: KOH mount of infected nail material showing fungal hyphae and conidia.

Culture: Cultures of S. brevicaulis are fast growing, vary in colour from white, cream, grey, buff to brown, black and are predominantly light brown.
Microscopy: Chains of single-celled conidia are produced in basipetal succession by a specialized conidiogenous cell called an annellide. Once again, the term basocatenate can be used to describe such chains of conidia where the youngest conidium is at the basal end of the chain. In Scopulariopsis, annellides may be solitary, in groups, or organized into a distinct penicillus. Conidia are globose to pyriform, usually truncate, with a rounded distal portion, smooth to rough, and hyaline to brown in colour.

Typical conidia of S. brevicaulis.

Comment: Most members of the genus Scopulariopsis are soil fungi, however a few, in particular S. brevicaulis, have been reported as causative agents of onychomycosis and hyalohyphomycosis.
About Scopulariopsis Back to virtual assessment